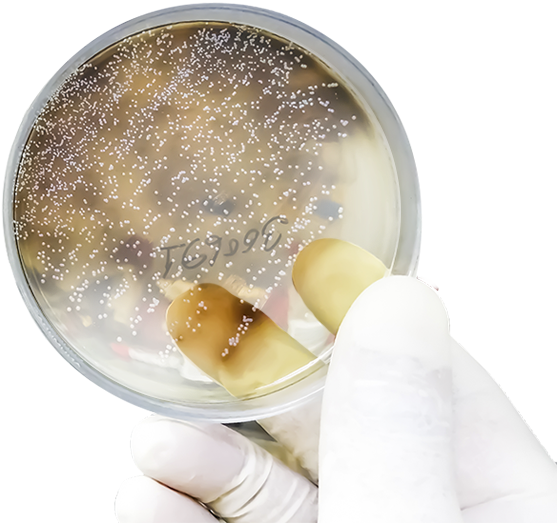

HealthHUB
12 травня 2022 року
16:00 – 18:00

інфекції сечовивідних шляхів.
Тандем гінеколога і нефролога
Рецидивуючі

Експерти зустрічі
Більченко Олександр Вікторович
Завідувач кафедрою кардіології, терапії та нефрології ХМАПО, ISN member, д.мед.н., професор
Геник Наталія Іванівна
Завідувач кафедри акушерства та гінекології ІФНМУ, професор
Експерти зустрічі
Більченко Олександр Вікторович
Завідувач кафедрою кардіології, терапії та нефрології ХМАПО, ISN member, д.мед.н., професор
Геник Наталія Іванівна
Завідувач кафедри акушерства та гінекології ІФНМУ, професор
Реєстрація за посиланням
За підтримки

Все буде Україна!

УКРАЇНСЬКИЙ МЕДИЧНИЙ МІЖДИСЦИПЛІНАРНИЙ АЛЬЯНС "ХЕЛСХАБ"
ТЕХНІЧНА ПІДТРИМКА
ТЕХНІЧНА ПІДТРИМКА
